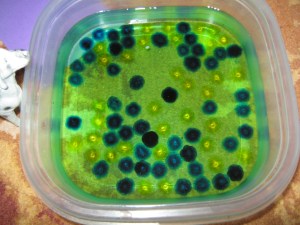

Dupa cate vad, multe sunt magice in postarile noastre 😀
Eu un cuvant ce il face pe D. sa devina foarte interesant de activitate…. 🙂
Este o activitate ce sigur ati zarit-o si pe alte bloguri.
Am cumparat 2 pungute cu bilute la 1,5 ron. Vara trecuta am cumparat si bilute si dinozauri. Aceste bilute puse in apa, cresc in cateva ore,marindu-si volumul de foarte multe ori. Dinozaurii de asta vara devenisera de la 2 cm fff uriasi; aveau vreo 10-11 cm. Danut ii lasase in apa, la soare :).
L-am lasat pe D. sa le puna in apa.
Isi lasa culoarea in apa, a noastra devenise albastruie.
Dupa o ora, aratau asa:
Si dupa vreo 4-5 ore, devenisera ca niste bilute MArbles, gata sa fie atinse de ursuleti. 🙂
Sunt foarte placute la atingere, pentru noi, tati de exemplu nu le suporta 😀 . Sunt ca niste jeleuri moi si reci :). Baietii le-au turnat in masinute, alte recipiente, le-au facut sa sara;pur si simplu si-au bagat manutele printre ele si se distrau de atingerea lor rece.
Daca le intepi cu unghia, se sparg imediat, de fapt sa faramiteaza in bucati.
LA vara, ne vom lua mai multe si ne vom juca cu ele in curte, pentru ca si acum mai gasesc cate o biluta prin casa. 🙂

februarie 25, 2012 la 09:13
Se pare ca mamicile au o super putere:comunica prin telepatie. Si noi ne-am jucat ieri cu bilute ca ale voastre.
februarie 25, 2012 la 22:24
🙂
Si le-au placut bilutele??
februarie 26, 2012 la 11:57
Le-au placut mult de tot.